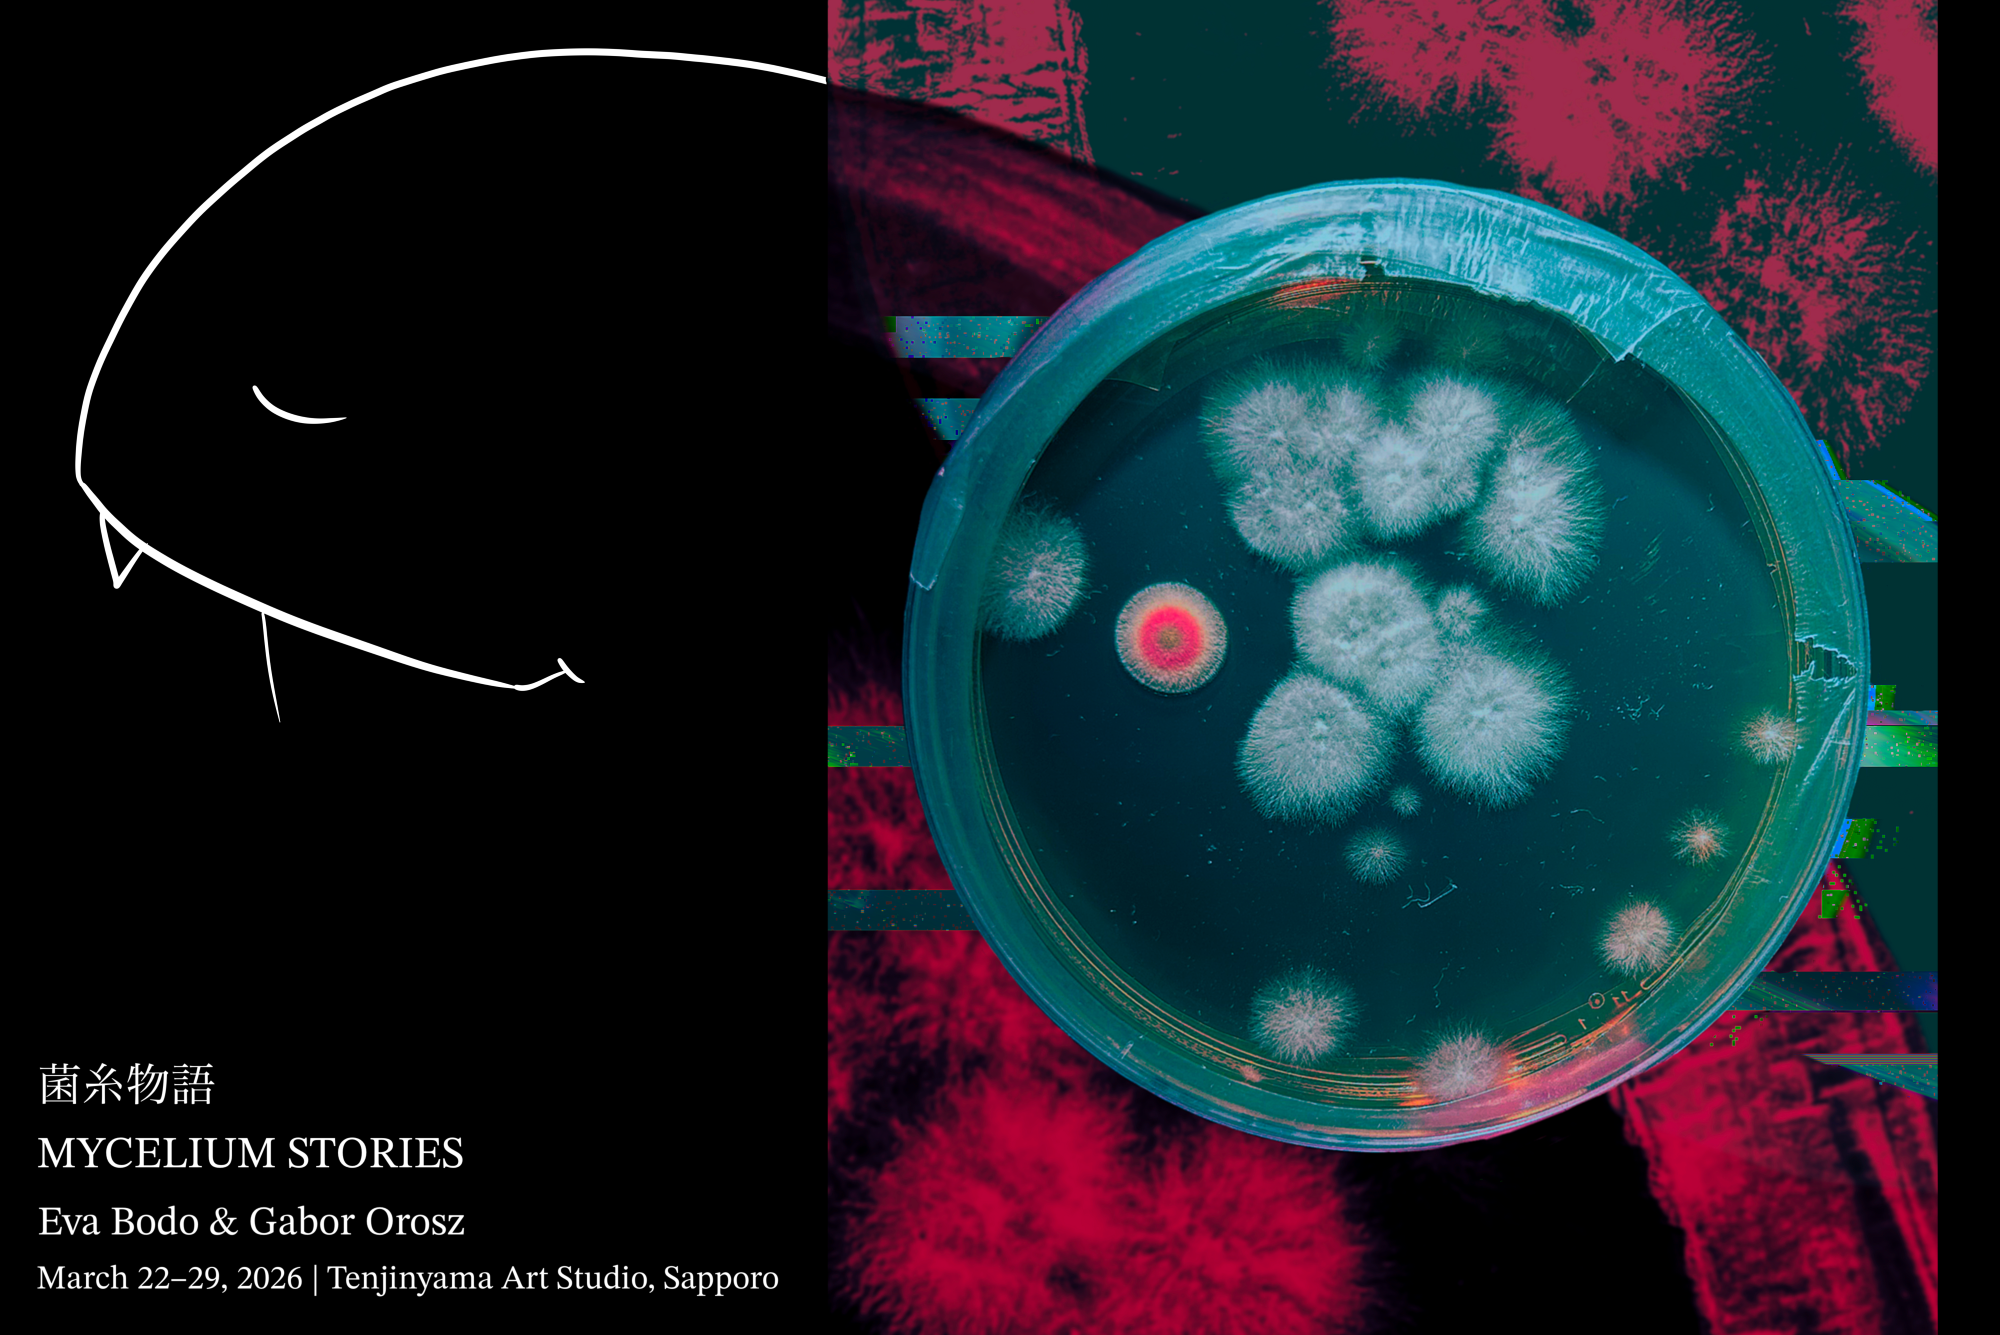
画像：記事のアイキャッチ

イベント
アーティスト
お知らせ
News 2026年3月4日
AIRディレクター小田井真美が令和7年度芸術選奨文部科学大臣賞を受賞しました。
News 2025年7月27日
滞在中の創造的活動について(利用規約2025.04版より一部抜粋)